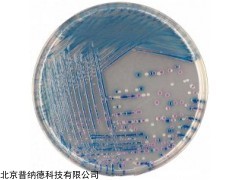

| 提交询价信息 |
| 发布紧急求购 |

价格:电议
所在地:北京
型号:1000ml
更新时间:2024-02-18
浏览次数:1103
公司地址:北京市大兴区庆祥南路29号院
![]()
王超(先生)
自成立以来,公司秉承:“普施利物,不于自身。诚纳于心,而践于行。宏志于道,而据于德”的经营发展理念。本着“专注、专业、高效”的工作态度, 公司依照可靠而稳定的产品质量和完善的售后服务确立了“pronade”良好的品牌形象。已经和国内多个科研院所、检验机构、生物制品企业、制药企业以及医疗卫生单位等建立了良好的合作关系。为客户提供zui适合的产品,是我们追求的zui终服务目标。普纳德已成为生物培养基以及相关产品专业的供应商;同时也是微生物检验产品专业的服务商。
普纳德公司一直致力于打造全球微生物培养及微生物检测产品集成平台。已经和多家世界著名的生物技术公司建立良好的合作关系。有效利用不同地域资源优势,从欧美生物技术发达国家引进优质原料;根据国内客户需求,提供高品质物美价廉的产品。
为满足不同客户的需求,公司还代理有:美国 BD、英国OXOID、biomerieux(法国梅里埃)、美国3M、CHROMagar(法国科玛嘉) 、西班牙pronadisa、美国LABM等品牌的产品。
 科玛嘉法国科玛嘉O157显色培养基,O157显色培养基用于分离鉴别食品中的大肠杆菌O157
科玛嘉法国科玛嘉O157显色培养基,O157显色培养基用于分离鉴别食品中的大肠杆菌O157
相比传统检测大肠杆菌的方法,利用山梨醇麦康凯琼脂培养基筛查,不仅需要经验丰富的专业技术人员检测,而且要从大量的菌群中挑选并区分出山梨醇阴性菌落,流程复杂繁琐,环境要求苛刻。法国科玛嘉O157显色培养基,O157显色培养基为您解决这一烦恼,利用的菌落显色技术(O157生长紫红色菌落,其他大肠杆菌生长紫红色菌落,其他大肠杆菌生长蓝色菌落),大大简化您的工作量。
具有高特异性&高敏感度的优点,24h内快速筛查诊断。
一、组分
琼脂 15.0g/L 蛋白胨、酵母粉 13.0g/L
色素 1.2g/L pH 7.0±0.2
可以根据需要进行经典配方的调整和/或补充。
二、操作
称取瓶内干粉,用1000ml蒸馏水或纯水溶解,可按29.2g/L的比例扩大或缩小。
将上述干粉缓慢倒入蒸馏水中,充分搅拌溶解。
加热至100℃,并按常规不断搅拌。如果用高压灭菌锅,不要加压,加热不能超过100℃。混合物也可以在微波炉内加热,煮沸后,立即移出微波炉并轻轻搅拌,而后再移入微波炉继续加热,直至琼脂等完全溶解(大量气泡代替泡沫产生,大约需要2分钟)。
将培养基冷却至45-50℃后,倾倒于培养皿或试管中。
注1:如果需要选择性更强的培养基,可在48℃时加入亚碲酸钾溶液,使zui终浓度为2.5mg/l。
注2:如果标本中含有较多的变形杆菌,可在48℃时加入头孢克肟,使其zui终浓度为0.025mg/l。
注3:如果标本中含有较多的假单胞菌和/或气单胞菌,可在48℃时加入西苏罗锭(头孢磺碇),使其zui终浓度为5mg/l。
 免责声明:以上所展示的[1000ml 法国科玛嘉O157显色培养基]信息由会员[北京普纳德科技有限公司]自行提供,内容的真实性、准确性和合法性由发布会员负责。
免责声明:以上所展示的[1000ml 法国科玛嘉O157显色培养基]信息由会员[北京普纳德科技有限公司]自行提供,内容的真实性、准确性和合法性由发布会员负责。